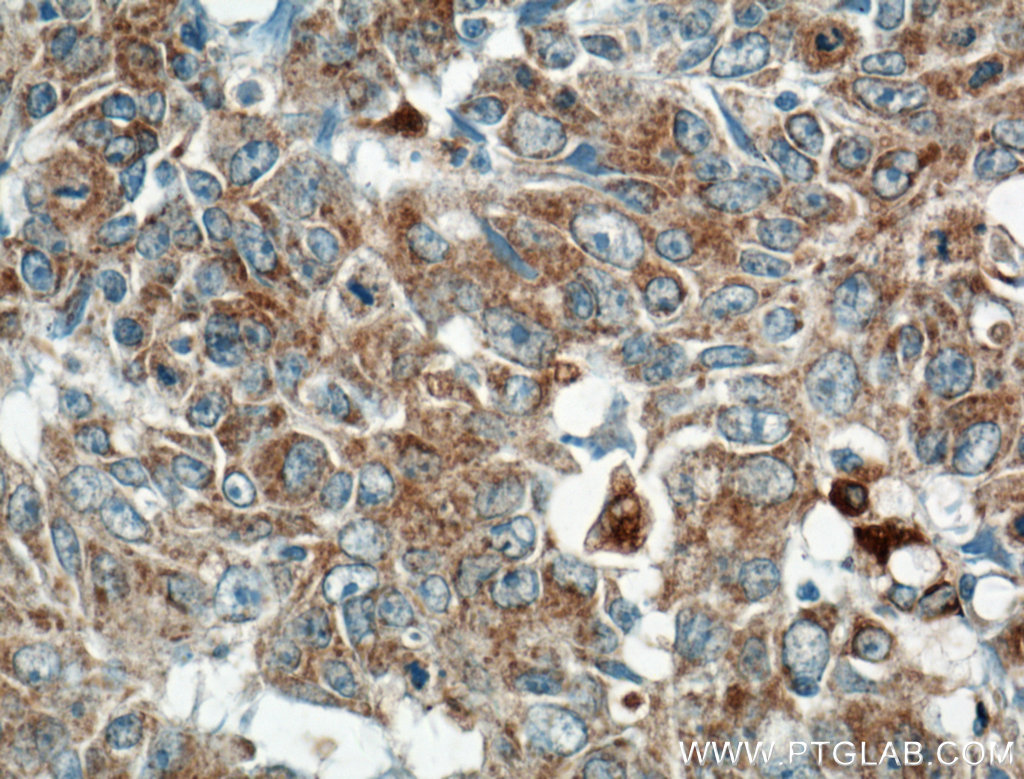
ARNTL Antibody 142681AP Proteintech

アリル炭化水素受容体核移行因子様タンパク質1(Aryl hydrocarbon receptor nuclear translocator like 1)はヒトのARNTL遺伝子にコードされたタンパク質である。ARNTLはBMAL1、MOP3とも呼ばれる。(あまり一般的ではないが、BHLHE5, BMAL, BMAL1C, JAP3, PASD3, TICという呼び名も用いられる)
ARNTL遺伝子にはベーシック-ヘリックス-ループ-ヘリックス(bHLH)と二つのPASドメインが含まれる。ヒトのARNTL遺伝子は24個のエクソンを持つと考えられており、第11染色体のp15バンドに位置する。BMAL1 タンパク質は626個のアミノ酸からなり、哺乳類における自家転写翻訳ネガティブフィードバックループ(TTFL)における正の因子の一つとして重要な役割を持ち、遺伝分子的な概日リズムにも関わる。また、BMAL1は高血圧症、 糖尿病、 肥満の関与遺伝子であることが予測されており、BMAL1変異は不妊や糖新生・脂質新生異常を引き起こし、睡眠パターンを変化させる。全ゲノム分析によって、BMAL1はヒトゲノムにおいて推定150以上領域を標的としており、全ての時計遺伝子や代謝制御タンパクをコードする遺伝子も含まれる。
歴史
ARNTL遺伝子は1997年、John B.Hogeneschのグループによって3月に 、池田・野村のグループによって4月に 、PASドメイン転写因子のスーパーファミリーの遺伝子として発見された。 ARNTLタンパク質はMOP3としても知られ、MOP4やクロック、低酸素誘導因子と二量体を形成することが分かっている。 BMAL1、ARNTLという名前は、近年の論文で採用されている。ARNTLタンパク質で最も初めに発見された概日制御における機能は、CLOCK-BMAL1(CLOCK-ARNTL)のヘテロ二量体に関係するもので、CLOCK-BMAL1はE-boxと結合しバソプレシン遺伝子の転写活性を亢進する。 しかし、概日リズムにおけるBMAL1遺伝子の重要性は、ノックアウトマウスが運動や他の行動において概日リズムを完全に喪失することが発見されるまで、完全には理解されていなかった。
構造
結晶構造から、BMAL1タンパク質は4つのドメイン含むことが分かっている: bHLHドメイン、PAS-!, PAS-Bと呼ばれる、2つのPASドメイン、トランス活性化ドメインである。CLOCK-BMAL1の二量体化にはCLOCKとBMAL1両者のbHLH, PAS A, PAS Bドメイン、それぞれの間での強い相互作用がかかわっており、3つの異なるタンパク質界面によって左右非対称のヘテロ二量体を形成する。CLOCK-BMAL1間でのPAS-Aの相互作用は、 CLOCK PAS-Aのα-ヘリックスおよびBMAL1 PAS-Aのβ-シート間での相互作用、BMAL1 PAS-Aのα-ヘリックスとCLOCK PAS-Aのβ-シート間での相互作用からなる。 CLOCKとBMAL1におけるPAS-Bドメインは並列して積み重なり、これによってBMAL1 PAS-Bのβ-シートやCLOCK PAS-Bのらせん状表面におけるTry 310やPhe 423などの疎水性残基をしまい込んでいる。 特異的なアミノ酸残基との重要な相互作用は、特にCLOCKのHis 84とBMAL1 Leu 125で起こり、CLOCK-BMAL1の二量体化に重要である。
機能
概日
哺乳類において、Bmal1遺伝子によってコードされるタンパク質は、PASドメインを介してカンドbHLH-PASタンパク質であるCLOCK(もしくはパラログのNPAS2)と結合し、核内でヘテロ二量体を形成する。 BHLHドメインを介して、このヘテロ二量体はPer(Per1, Per2)やCry(Cry1, Cry2)のプロモータ領域に位置するE-box応答領域と結合する。この結合はPER1, PER2, CRY1, CRY2タンパク質の転写翻訳を促進する。
PERとCRYタンパク質が十分量まで蓄積すると、PASモチーフを介して相互作用し、核内に移行してCLOCK-BMAL1ヘテロ二量体の転写活性を阻害する抑制複合体を形成する。 この二量体はPerとCry遺伝子の転写を抑制し、PERとCRYのタンパク質レベルを減少させる。 この転写翻訳ネガティブフィードバックループ(TTFL)は、細胞質内でカゼインキナーゼ1εやδ(CK1εやCK1δ)によるPERタンパク質のリン酸化によって修飾され、これらのタンパク質の26Sプロテオソームによる分解を仲介する。 SIRT1もBMAL1-CLOCKのヘテロ二量体を脱アセチル化させ、概日的なPERタンパク質の分解を制御している。 PERタンパク質の分解は大型のタンパク質複合体の形成を阻害し、これによってBMAL1-CLOCKヘテロ二量体による転写活性阻害作用を妨害する。CRYタンパク質もFBXL3タンパク質によってポリユビキチン化による分解を引き起こされ、同じくBMAL1-CLOCKヘテロ二量体の阻害作用が妨害される。これによってPerとCry遺伝子の転写が再開される。夜行性マウスのTTFLループにおいて、Bmal1遺伝子の転写レベルのピークはCT18にみられ、これは主観真夜中で、Per,Cryなどの主観真昼のCT6にピークを持つ時計遺伝子とは逆位相をとる。このプロセスは約24時間の長さを持ち、これは分子メカニズムがリズム性であるという考えを支持する。
Bmal1活性の制御
上述したTTFLループの概日制御に加えて、Bmal1転写はBmal1のプロモータに含まれる、レチノイン酸関連オーファン受容体応答領域結合サイト(RORE)によっても制御される。CLOCK-BMAL1ヘテロ二量体は、Rev-ErbやROR遺伝子のプロモータ領域に存在するE-boxにも結合し、REV-ERBやRORタンパク質の転写翻訳を促進する。REV-ERBαやRORタンパク質は、セカンダリーフィードバックループを介し、競合してBmal1プロモータ内のREV-ERB/ROR応答領域に結合し、BMAL1発現を制御する。同じファミリー内の他の核受容体(NR1D2(Rev-erbβ);NR1F2(ROR-β);NR1F3(ROR-γ))も、Bmal1転写活性に同じように作用する。
複数のBMAL1の翻訳後修飾はCLOCK/BMAL1のフィードバックループを指示する。BMAL1はリン酸化によってユビキチン化、分解の標的となる。BMAL1のアセチル化はCRY1をリクルートし、CLOCK/BMAL1のトランス活性化を抑制する。 小型のSUMO3によるBMAL1のSUMO化は、核でのBMAL1のユビキチン化の合図となる。これによって、CLOCK/BMAL1ヘテロ二量体のトランス活性化が誘発される。 CLOCK/BMAL1のトランス活性 は、カゼインキナーゼ1εによるリン酸化によって亢進され、MAPKによるリン酸化によって抑制される。 CK2αによるリン酸化はBMAL1の細胞内局在を制御し、 GSK3Bによるリン酸化はBMAL1の安定性をコントロールし、リン酸化を誘発する。
その他の機能
Arntl遺伝子はラットにおいて、第1染色体の高血圧推定遺伝子座に存在する。 この座位の一塩基多型 (SNPs)研究によって、Arntlをコードする配列において2つの多型が発見された。この部分はII型糖尿病と高血圧に関連している。 ラットモデルをヒトモデルに適用した時、この研究からArntl遺伝子多型のII型糖尿病病理の原因に関わる働きが示唆された。 最近の表現型データから、 ArntlやパートナーのClockは 、グルコース恒常性や代謝に関わっていると示唆されており、これら遺伝子の破壊によって高インスリン症や糖尿病が引き起こされる。 他の機能に関して、ある研究ではCLOCK/BMAL1複合体がヒトのLDLRプロモータの活性を亢進することが示されており、このことからArntl遺伝子はコレステロール恒常性にも関わると示唆されている。 加えて、Arntl遺伝子は他の時計遺伝子の発現と連動しながら発現するが、双極性障害では低下することが分かっている。 Arntl、Npas2、Per2もまた、ヒトの季節性情動障害に関わっている。 最後に、Arntlは機能性遺伝子診断によって、P53遺伝子経路の有力な制御子であることが同定された。これはがん細胞での概日リズムにArntlが関わっていることを示唆する。
ノックアウト研究
Arntl遺伝子は哺乳類時計遺伝子制御ネットワークの重要な構成要素である。 ネットワーク感受性における重要な点は、モデルマウスで一つの遺伝子をノックアウトさせただけで分子および行動のリズム性が失われるということである。 時計への異常に加えて、Arntl nullのマウスは生殖異常のほかに、低身長、早老 、進行性関節症 を示し、その結果、野生型よりも運動量が低下する。 しかし、最近の研究から、ArntlとパラログのBmal2のあいだで、概日機能における機能重複が存在するということが示唆されている。
相互作用
Arntlは以下の遺伝子と相互作用する :
- アリール化炭化水素受容体
- CLOCK
- CREBBP
- CRY1
- EP300
- EPAS1
- HIF1A
- NPAS2
- SUMO3
参照
- Arntl2 - Arntl(Bmal1)パラログ。helix-loop-helix PASドメイン転写因子をコード。 BMAL2タンパク質はCLOCKタンパク質とヘテロ二量体を形成。低酸素症にも関わる。
- Cycle - ショウジョウバエにおけるオルソログ。
- アリル炭化水素受容体核内移行因子(Aryl hydrocarbon receptor nuclear translocator: ARNT) - ARNTLの名の元になっている。
- アリル炭化水素受容体(Aryl hydrocarbon receptor: AhR) - 上記の名の元。
参考文献
外部リンク
- Human Human ARNTL genome location and ARNTL gene details page in the UCSC Genome Browser.UCSC Genome BrowserHuman ARNTL genome location and ARNTL gene details page in the UCSC Genome Browser.